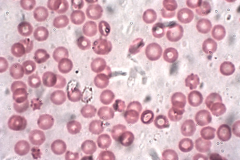

生活科普:寶寶愛出汗咋回事
生活科普:寶寶愛出汗咋回事
生命時報
06-23
2021

科普小知識:電影是誰發(fā)明的?
科普小知識:電影是誰發(fā)明的?
許多小朋友還有大人都喜歡看電影。電影里有五彩斑斕的世界,還有許多現(xiàn)實中不存在的神奇動物和秘密天地。
中國數(shù)字科技館
06-23
2021

科普小知識:電腦里的cookies是什么?
科普小知識:電腦里的cookies是什么?
我們在用電腦上網(wǎng)的時候,經(jīng)常會看到瀏覽器彈出一些對話框,里面講到什么cookies這個東西,問你要不要把它關(guān)掉。
中國數(shù)字科技館
06-23
2021

科普小知識:為什么會胃疼?
科普小知識:為什么會胃疼?
在節(jié)假日,許多小朋友會借機吃很多東西。有時候你的肚子就會和你鬧別扭了。有些小朋友會胃疼,真不好受啊。
中國數(shù)字科技館
06-23
2021
科普小知識:身體里為什么會有水
科普小知識:身體里為什么會有水
不管你信不信,我們身體里大部分成分都是水。但是很明顯,我們的身體平時不會往外亂噴水、濺水。那么這些水一定是好好地保存在我們身體里咯?
中國數(shù)字科技館
06-23
2021

生活科普:為什么單身的人聞起來不一樣?
生活科普:為什么單身的人聞起來不一樣?
新浪科技
06-23
2021

生活科普:要多“硬”的床,才能撐起一個疲憊的腰?
生活科普:要多“硬”的床,才能撐起一個疲憊的腰?
生命時報
06-23
2021

生活科普:人到中年,喝茶要注意,掌握三喝三不喝,喝茶才能喝出健康來
人到中年,喝茶要注意,掌握三喝三不喝,喝茶才能喝出健康來
王桂真營養(yǎng)師
06-23
2021

生活科普:戒指開啤酒瓶?這回交了“智商稅”!
戒指開啤酒瓶
國家應(yīng)急廣播
06-23
2021

科學(xué)證明:誰偷走了人類三歲之前的記憶?
科學(xué)證明:誰偷走了人類三歲之前的記憶?
首先問你一個嚴肅的問題,現(xiàn)在回想一下,在你的腦海中還有3歲之前的記憶嗎?
無知君頭條號
06-22
2021
 會員登錄
會員登錄



















